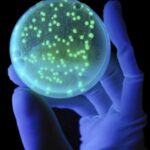

Од раното детство почнуваме да тренираме внимание и меморија со учење песни, странски јазици и решавање загатки. Меѓутоа, со возраста, оваа важна способност на мозокот почнува да „рѓосува“, а тоа може да биде предизвикано не само од возраста, туку и од голем број други неповолни фактори.
Кои навики ја оштетуваат меморијата и како да ги надминете?
Нарушената меморија е една од главните последици на дигиталната деменција – нова болест на нашето време. Под овој поим лекарите подразбираат влошување на менталните способности на човекот поради секојдневна употреба на апаратот, што е придружено и со потешкотии во согледувањето на информациите и недостаток на критичко размислување, пишува магазинот City.
„Електронските уреди го спасуваат човекот од прекумерна ментална активност. Секако, тоа многу ни го поедноставува животот, но како мозокот, кој е одговорен за менталната функција на телото, реагира на таквата „помош“? Недостатокот на работа на овој важен орган доведува до постепено уништување на нервните врски, што пак значително ги забавува процесите што се случуваат во мозокот“, вели германскиот невролог, психијатар на Медицинскиот и природниот факултет во Улм, проф. . Верба Мајр Манфред Спицер.
Освен влијанието на уредот, на работата на мозокот и меморијата негативно влијаат и бројни други навики со кои секојдневно се среќава современиот човек.
Недостаток на спиење
Лекарите постојано повторуваат дека правилниот одмор е клучот за менталното и физичкото здравје. За време на спиењето се обновува работата на мозокот, се развива неговата способност за учење, се неутрализираат негативните спомени и се стабилизира емоционалната состојба. Покрај тоа, експертите сметаат дека спиењето е многу важно за зачувување на меморијата, бидејќи во отсуство на него, круговите на меморијата се преоптоваруваат и се влошува способноста на мозокот да ги согледа и асимилира информациите.
Премногу информации
Секој од нас е во бесконечен проток на информации. Секојдневно добиваме многу пораки од различни извори и престануваме да ги разликуваме важните информации од непотребните. Прекумерната содржина е сериозен стрес за мозокот, што доведува до појава на фрагментирани размислувања, лишени од критики. Покрај тоа, преоптоварувањето со информации може да предизвика проблеми со меморијата, концентрацијата и донесувањето одлуки.
Неправилна исхрана
Докажано е дека честото консумирање брза храна и богата со заситени масти, шеќери и соли предизвикува одредени когнитивни нарушувања кај човекот, како и влошување на краткотрајната меморија. Тоа е затоа што навиките во исхраната влијаат на функционирањето на хипокампусот, областа на мозокот која е одговорна за меморијата. Лекарите препорачуваат одговорен пристап кон оваа тема, бидејќи во спротивно ризиците од развој на деменција, дијабетес и дебелина значително се зголемуваат.
Пасивен начин на живот
Седечкиот начин на живот е уште еден чест фактор кој негативно влијае на меморијата. Постои врска помеѓу недоволната физичка активност и способноста на човекот да учи. Факт е дека долгиот престој во истата положба го намалува протокот на крв во мозокот и го ограничува снабдувањето со кислород и хранливи материи потребни за неговото нормално функционирање. Недостатокот на физичка активност ја нарушува краткорочната меморија на личноста и може да доведе дури и до Алцхајмерова болест.
Вршење повеќе работи одеднаш
Многумина од нас живеат во режим „направи сам“. Навикнати сме да правиме неколку работи истовремено и да решаваме многу проблеми. Меѓутоа, во повеќето случаи, ваквиот начин на размислување само му штети на нашето здравје, бидејќи нè принудува да се префрламе од една на друга задача, што ни ја затапува способноста да размислуваме креативно и да размислуваме надвор од рамката. Покрај тоа, постојаниот стрес зад голем број задачи негативно влијае на работата на кардиоваскуларниот систем и емоционалната состојба.
Можете да ги подобрите навиките кои ја загрозуваат меморијата само кога ќе го преиспитате вашиот животен стил. Прилагодете ја вашата исхрана, внесете редовни физички активности во вашата дневна рутина и дозволете му на телото целосно да се опушти.
Покрај тоа, дигиталната детоксикација ќе помогне да се зачува меморијата. Привремено одбивање да се користи уредот ќе помогне да се врати целосната функција на мозокот и да се активираат важни мисловни процеси. Ако е невозможно целосно да го напуштите паметниот телефон, обидете се барем малку да го намалите времето што го поминувате пред екранот.